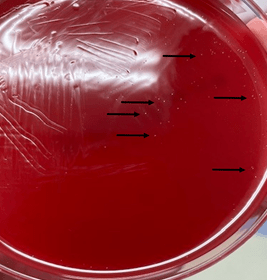

Case History
A 32 year old male with alcoholic cirrhosis presented to the emergency department with progressive lower extremity swelling. On presentation he was found to have jaundice due to hemolytic anemia secondary to spur cell anemia. Admission hemoglobin was 4.3 mg/dL (4.0-11.0 mg/dL) and bilirubin, both total and direct, were 6.3 mg/dL (0.2-1.3 mg/dL) and 2.9 mg/dL (0.0-0.5 mg/dL), respectively. He also had acute kidney injury (AKI) thought to be secondary to hepatorenal syndrome leading to the development of anasarca. A urinalysis was performed as part of the evaluation for his AKI that showed 100 WBC/HPF, > 187 RBC/HPF, and moderate bacteria which triggered a urine culture.
Laboratory Identification
Urine received in the microbiology laboratory was plated on Blood and MacConkey/CNA agars and grew non-hemolytic, lactose-fermenting gram negative rods (Image 1). Indole testing was negative. Given this biochemical pattern, a member of the Enterobacterales was suspected as typically seen in urine cultures. However, MALDI-TOF MS provided the surprising identification of Salmonella enterica subsp. arizonae. Xylose Lysine Deoxycholate (XLD) agar was set up to confirm the unusual identification (Image 2). Hydrogen sulfide production is typical of Salmonellae, and lactose fermentation, a trait unique to some isolates of S. enterica subsp. arizonae, was confirmed. The organism was submitted to the Texas Department of Health laboratory where the isolate was definitively identified as Salmonella enterica subsp. arizonae (IIIa 14:z4,z23) by whole genome sequencing.


Discussion
This is a rare case of an extraintestinal infection caused by Salmonella enterica subsp. arizonae. Salmonellaeare motile, gram negative, facultatively anaerobic bacilli that are members of the Enterobacterales. The genus is composed of two species, S. enterica and S. bongori. Salmonella enterica is further subdivided into six subspecies: enterica (group I), salamae (group II), arizonae (group IIIa), diarizonae (group IIIb), houtenae (group IV), and indica (group VI). Salmonella bongori used to be classified as group V but was separated as a unique species based on genomic analysis.1 S. bongori almost exclusively causes zoonotic infections, while S. enterica subsp. enterica is the most frequent cause of human clinical disease. Salmonella taxonomy is complicated further by the division of members of S. enterica subsp. enterica into >2500 unique serovars based on immunoreactivity to lipopolysaccharide (O) and two flagellar (H) surface antigens. These are then further separated into “typhoidal” and “non-typhoidal” serovars based upon the characteristics of infection (Image 3).

Until recently, determinative testing was almost uniformly performed by serological confirmation of agglutination with O and H antigen-specific antisera. This has been a mainstay of epidemiological analysis of foodborne Salmonella outbreaks. Only recently has whole genome sequencing been adapted as a higher throughput and more discriminatory alternative to classical serotyping schemes. Salmonella nomenclature often uses a genus-species-subspecies format followed by serovar (e.g. Salmonella enterica subsp. enterica serovar Typhi), or it can be reported as genus-serovar for short (e.g. Salmonella Typhi). Formal identification will include information concerning the two flagellar antigens and lipopolysaccharide antigens, in addition to the formalized subspecies using the formula: genus-species-subspecies [space] O antigens [colon] Phase 1 H antigen [comma] Phase 2 H antigen. In this case, the formal identification from the state laboratory for this isolate was Salmonella enterica subsp. arizonae IIIa 14:z4,z23.
About 99% of human infections are due to Salmonella enterica subspecies enterica (group I)including the serotypes Enteritidis, Typhimurium, Typhi, Paratyphi.2 Infections due to Salmonella enterica subspecies arizonae are rare; serovar IIIa 41:z4,z23 is associated with 10-20 infections per year.3 Infection typically begins as gastroenteritis from food poising or from animal sources, particularly reptiles or poultry. Disease is typically seen in the young and immunocompromised and can progress to invasive disease including sepsis, meningitis, and osteomyelitis.4 It is unclear why there are lower rates of Salmonella enterica subspecies arizonae infections in humans as compared to Salmonella enterica subspecies enterica, but there is evidence to suggest Salmonella enterica subspecies arizonae and diarizonae have altered intestinal colonization in murine models leading to failure of Salmonella to persist in the mammalian intestinal tract.5
This patient had alcoholic cirrhosis and uncomplicated cystitis secondary to Salmonella extraintestinal infection at the time of presentation. It is unclear if this patient had gastroenteritis prior to developing cystitis and the limited medical history did not reveal exposure to reptiles or poultry. In this case, the patient completed seven days of ceftriaxone without complication or recurrence of infection.
References
- Agbaje M, Begum RH, Oyekunle MA, Ojo OE, Adenubi OT. Evolution of Salmonella nomenclature: a critical note. Folia Microbiol (Praha) 2011; 56(6): 497-503.
- Brenner FW, Villar RG, Angulo FJ, Tauxe R, Swaminathan B. Salmonella nomenclature. J Clin Microbiol 2000; 38(7): 2465-7.
- Shariat NW, Timme RE, Walters AT. Phylogeny of Salmonella enterica subspecies arizonae by whole-genome sequencing reveals high incidence of polyphyly and low phase 1 H antigen variability. Microb Genom 2021; 7(2).
- Abbott SL, Ni FC, Janda JM. Increase in extraintestinal infections caused by Salmonella enterica subspecies II-IV. Emerg Infect Dis 2012; 18(4): 637-9.
- Katribe E, Bogomolnaya LM, Wingert H, Andrews-Polymenis H. Subspecies IIIa and IIIb Salmonellae are defective for colonization of murine models of salmonellosis compared to Salmonella enterica subsp. I serovar typhimurium. J Bacteriol 2009; 191(8): 2843-50.
- Achtman M, Wain J, Weill FX, Nair S, Zhou Z, et al. (2012) Multilocus Sequence Typing as a Replacement for Serotyping in Salmonella enterica. PLOS Pathogens 8(6): e1002776. https://doi.org/10.1371/journal.ppat.1002776
–Denver Niles, MD is the Medical Microbiology fellow at UT Southwestern Medical Center. Prior to his Medical Microbiology fellowship, he completed pediatric infectious disease training at Baylor College of Medicine/Texas Children’s Hospital.
–Muluye Mesfin, SM(ASCP)CM is the microbiology laboratory supervisor at UT Southwestern Medical Center where he has worked for 12 years. Prior to this, Mo completed a bachelor of science degree in medical technology at the University of Maryland.

-Clare McCormick-Baw, MD, PhD is an Assistant Professor of Clinical Microbiology at UT Southwestern in Dallas, Texas. She has a passion for teaching about laboratory medicine in general and the best uses of the microbiology lab in particular.

-Andrew Clark, PhD, D(ABMM) is an Assistant Professor at UT Southwestern Medical Center in the Department of Pathology, and Associate Director of the Clements University Hospital microbiology laboratory. He completed a CPEP-accredited postdoctoral fellowship in Medical and Public Health Microbiology at National Institutes of Health, and is interested in antimicrobial susceptibility and anaerobe pathophysiology.